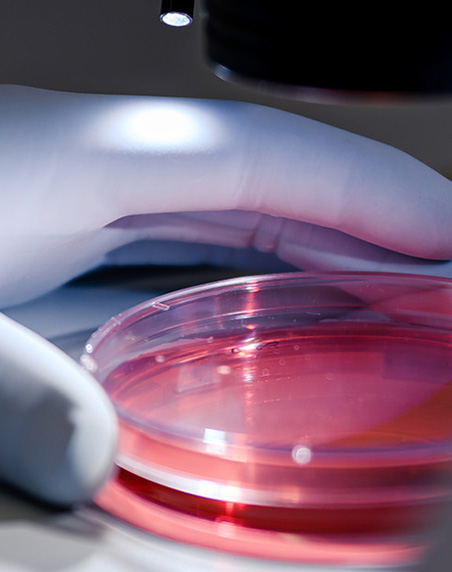

2026 HSBC innovation horizons report
Unpack fresh insights on the near and long-term economic impacts of AI, from the macro to micro level, sector by sector, for the innovation ecosystem and beyond.

Articles

HSBC Startup Banking is paving the way for early-stage companies

2025 mid-year venture healthcare report

Convergence, emergence & resurgence - 2025 fintech report

Innovations horizon 2025: resetting the venture economy for AI era

Health 2035: redefining trust, technology, and tomorrow’s care

From seed to speed: leveraging advisors to accelerate startup growth
HSBC venture healthcare 1H 2024: mid-year insights

Looking Beyond Equity: The Role of Venture Debt and Growth Capital for the Innovation Ecosystem

The art and science of valuing your start-up

Bootstrapping versus venture capital

Accessing funding in a downturn

How to: Create a compelling investor pitch

HSBC venture healthcare report: 2024 year-end recap

HSBC venture healthcare report: 2023 year-end recap

HSBC venture healthcare 1H 2023: mid-year insights
Disclaimer
*HSBC Innovation Banking is a business division with services provided in the United States by HSBC Bank USA, N.A.
DO NOT include personal/account information in this form. Please contact using the business customer service center phone number to discuss any account questions.
Deposit products offered in the United States by HSBC Bank USA, N.A. Member FDIC.
For clients located outside of the U.S. – Our products and services are not specifically directed at individuals located in the European Union. Our U.S. representatives, as well as our public website, us.hsbc.com, provide products and services governed by U.S. laws and regulations. Our products and services, as well as their specific terms and conditions, are subject to change and may not be available in all territories or to all customers. If you are not located in the U.S., the laws and regulations of your country of residence could affect the offering, negotiation, discussion, provision, and/or use of HSBC U.S. products and services. If you are not a U.S. resident, please read the specific cross-border product and service disclaimers, which are available on the Cross Border Disclosure page of our public website at www.us.hsbc.com/crossborder. Deposit products are offered in the U.S. by HSBC Bank USA, N.A. Member FDIC. Lending products are offered in the U.S. by HSBC Bank USA, N.A. Investments and certain insurance products, including annuities, are offered by HSBC Securities (USA) Inc. (HSI), member NYSE/FINRA/SIPC. Whole life, universal life, term life, and other types of insurance are provided by unaffiliated third parties and offered through HSBC Insurance Agency (USA) Inc., a wholly owned subsidiary of HSBC Bank USA, N.A.
* Limitations apply. International calls cover over 190 countries including Western Europe, Canada, Mexico, China and India.